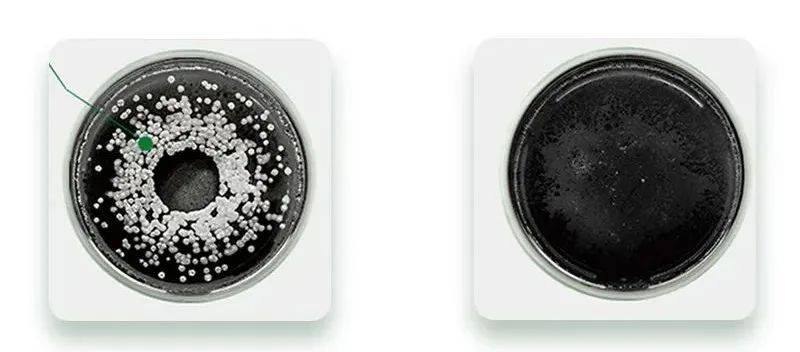
洗头花几千块做头皮清洁,到底是不是智商税?

其实 , 头发是否健康关键在于头皮 , 而发丝本身是没有生命的 。
想要拥有一头健康的头发 , 我们需要定期进行头皮清洁 , 清理干净毛囊油脂才行 。
所以 , 总结一下 , 头皮清洁必不可少 。
虽然头皮清洁很重要 , 但对小N来说 , 花大几千买个套餐还是贵了点 。

文章图片
其实 , 头皮清洁自己在家也完全可以搞定 。
比如 , 小N家的这款N.ze澳洲茶树头皮清洁膏 , 它就像一个“头皮吸尘器” , 让你在家就能享受沙龙级SPA护理 , 享受头皮深层清洁带来的清爽感 。
每周2次深层清洁
让你的头皮年轻10岁

文章图片
这款头皮清洁膏主打的是澳洲茶树精油这个精华成分 。

文章图片
对护肤有兴趣的小姐姐 , 应该都听过茶树精油的大名 。
茶树精油是顶级的天然抗菌剂 , 被称为“自然界中的抗菌大师”“澳大利亚的液体黄金” 。

文章图片
它不仅能够抗菌消炎 , 还能调节油脂平衡、收敛毛孔 。

文章图片
N.ze头皮清洁膏添加的茶树精油 , 源自N.ze澳洲主营地集团茶树庄园 , 这里是世界优质精油产地 。

文章图片
80平方公里的种植面积 , 年产茶树精油占世界产量50% 。

文章图片
独创3U提取工艺 , 保证了每一滴精油的天然、纯正 , 其中松油烯-4-醇含量≥40% , 远高于国家标准 。

文章图片
引自国标 《GB/T 26514-2011》
茶树精油有多神奇?
1980年 , 澳大利亚的实验表明:以4:1000的稀释比率调和茶树精油与水 , 检验其杀菌能力 , 它能完全消除白色念珠菌、金黄色葡萄球菌、大肠杆菌、马拉色菌等高传染病菌 。
文章图片
N.ze头皮清洁膏里面添加了1%的澳洲茶树精油 。
它能够快速渗透进入毛囊 , 清除掉堵塞毛囊的油脂颗粒、垃圾 , 让你的头皮远离油腻困扰 。

文章图片
不仅如此 , 茶树精油还能轻松杀灭头屑罪魁祸首——马拉色菌 。

文章图片
除了茶树精油外 , 它还添加了天然海盐颗粒 。
海盐能有效渗透头皮表层 , 由内而外的进行深层清洁 。 在头皮上揉搓时 , 就像是在按摩疏通毛孔 。

文章图片
海盐中含有镁、溴、钙3种元素 , 它们能穿透螨虫薄膜 , 使得虚弱的螨虫脱水而死 。
此外 , 这款头皮清洁膏还添加了足足9款珍贵植萃精华 。

经验总结扩展阅读
- 朝雾夕初春顶奢,惊艳绽放,花仙子路过人间
- 品牌人家花几万光子嫩肤,我劝你花一百多省下这笔钱!
- 花花公认好用的5款“素颜霜”:阿玛尼口碑好,斯黛娜性价比高
- 烫发 刚烫发第二天就洗头发,头发就不太卷了,烫发后多久可以洗头发?
- 高空30+女星保养太拼命,伊能静每年花7位数护肤,她50岁做高空运动?
- 花近女花近3万元做鼻综合手术,术后鼻子凹陷明显,竟因医生漏做项目
- 品牌拒绝无效防晒!别再花冤枉钱了!
- 因为刚烫发第二天就洗头发,头发就不太卷了,烫发后多久可以洗头发?
- 发型洗发水用完,可以用洗面奶洗头吗?结果是:头发油腻了发型也塌了
- 短发 染发前不洗头会比较安全?确实是,同时还要注意这4个方面!
